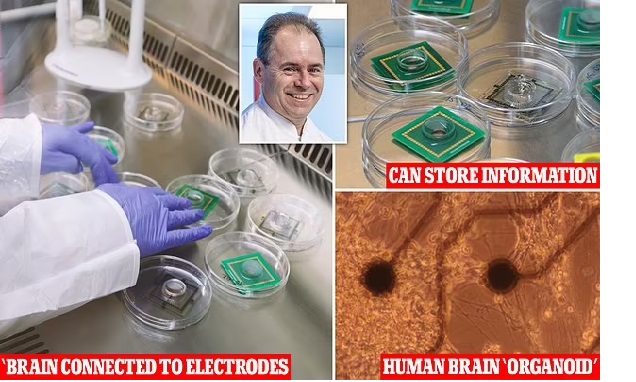
Computer made out of human BRAINS could solve the world's energy crisis - here's the scientist making science fiction reality

Computer made out of human BRAINS could solve the world’s energy crisis – here’s the scientist making science fiction reality
There is a lot of fear about robots replacing human. But maybe it should be the machines worrying about us.
Swedish scientists have created the world’s first ‘living computer’ that is made out of human brain tissue.
It composes of 16 organoids, or clumps of brain cells that were grown in a lab, which send information between each other.
They work much like a traditional computer chip – sending and receiving signals through their neurons that act like circuits.
But what makes them special is that the living machine uses less energy because living neurons can use over a one million times less energy than the current digital processors currently used.

When compared with the best computers in the world, such as Hewlett Packard Enterprise Frontier, the scientists found that for the same speed and 1,000 times more memory the human brain uses 10 to 20 watts -compared to the computer using 21 megawatts.
One megawatt is equal to one million watts.
The living machine was developed by scientists at FinalSparks, which focuses on creating solutions with biological neural networks.
Dr Fred Jordan, co-CEO of FinalSpark, a startup the focuses on creating solutions with biological neural networks, told DailyMail.com: ‘ This idea is common in science fiction, but there hasn’t been a huge amount of real research into it.’
Organoids are tiny, self-organized three-dimensional tissue cultures made from stem cells.
Such cultures can be crafted to replicate much of the complexity of an organ, or to express selected aspects of it like producing only certain types of cells.
Scientists take the stems cells and cultivate them for about one month until they form features like neurons.
FinalSparks mini brains were built from an estimated 10,000 living neurons, about 0.5 mm in diameter.


The organoids are trained with doses of dopamine – when they perform tasks correctly they get a stream of the chemical as a reward.
Scientist administer dopamine by exposing a certain area of the brain organoid to light – similar to how it is released in the human brain when a certain region is activated.
The mini brains are surrounded by eight electrodes that measure activity in the organoids, and the researchers can send current through the electrode to influence the neuron.
These electrodes perform the dual role of stimulating the organoids and recording the data they process.
The organoids are also housed in a microfluidic incubator that acts as a mini plumbing system for tiny amounts of liquids, providing nutrients to the cells, and are provided nutrients necessary to keep them alive.
The incubator keeps the organoids at body temperature and automates the flow and maintenance of cellular media, providing a stable environment free of bacteria and viruses.
The cells in the ‘living computer’ live and die within 100 days, clumped together in a 3D organoid structure.
But they are similar to the ones in real human brains, and have similar electrical activity.

‘The neurons in your brain will live for about 80 years – you have the same ones when you die as when you are born. We are not as good as nature at keeping them alive, so they live for 100 days.’
And scientists just grow new organoids to replace the dead ones.
The team recently launched the brain computer as an online platform enabling global researchers to conduct experiments remotely on biological neurons in vitro.
Already, three dozen universities have expressed interest in using the platform
Jordan described the ‘living computer’ as ‘wetware’ because – like actual human brains – it’s somewhere between computer hardware (i.e. the chips which process information) and software (the programs that run on the hardware).
‘We call it ‘wetware’ – I don’t know who created the word – but the brain is between software and hardware,’ Jordan said.
‘In computers, you have a clear separation, you run different software on the same hardware.


‘But in our brain, in order to learn anything, you physically change the hardware that makes the synaptic connections. So we need a new word, and ‘wetware’ makes sense because cells need a wet environment to survive.’
The world is in the middle of an energy crisis due to fuel shortages, supply chain disruptions, geopolitical tensions and the transition to renewable energy.
Not to mention the rise of AI that is predicted to use 29.3 terawatt hours per year – one terawatt is equal to one trillion watts.
what are the next steps?
For now the company’s focus is on cloud computing, in particular the energy-hungry data centers which drive AI.

Labs and universities all over the world are already connecting to FinalSpark to test the hardware.
Later this month, Jordan will visit he world’s first ‘biocomputing’ conference will take place in Vienna this month, with visitors from Australia and the U.S: ‘I don’t think the organizers knew how few of us there are,’ he laughed.
He said that ever since publishing his findings, the phone hasn’t stopped ringing: ‘A lot of people are calling to offer me money,’ he said.
Another potential breakthrough is a new understanding of the human brain itself, which may lead to cures for diseases.
The technology to create organoids is relatively new, and there has been little research into the idea of turning human neurons into a computer before.
Source: daily mail
Entanglement used as fuel for quantum engines in new Chinese study
Computer made out of human BRAINS could solve the world’s energy crisis – here’s the scientist making science fiction reality